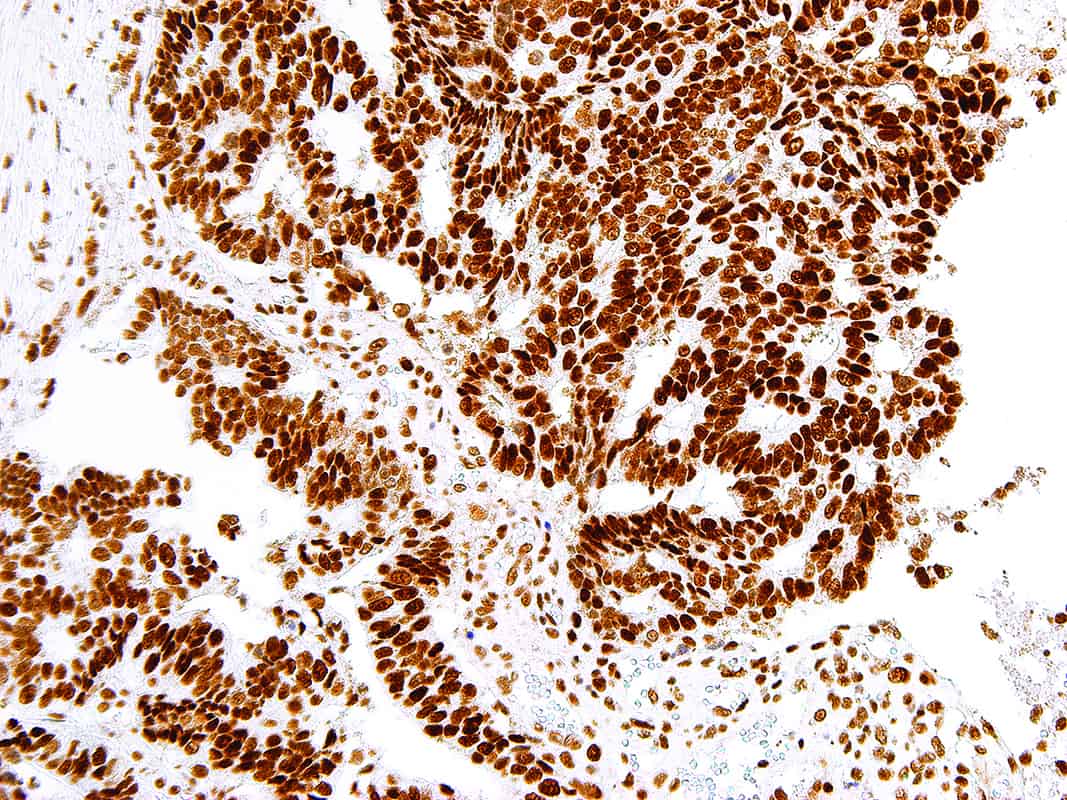
MSH2 | Medical Supply Company

MSH2
MutS Homolog 2 (MSH2) is a protein involved in the mismatch-repair pathway. This protein is commonly associated with hereditary non-polyposis colorectal cancer, and mutations in this gene are correlated with the development of sporadic colorectal carcinoma. Expression levels of MSH2 are abnormally low in a high percentage of patients with microsatellite instability, as well as endometrial and ovarian cancers. Use of Anti-MSH2 is optimized when paired in an IHC panel with antibodies against MSH6, MLH1, and PMS2. Reports have shown Anti-MSH2 to be useful in the detection of the protein in a number of normal and neoplastic tissues, and for identifying a loss of MSH2 in tumors that are microsatellite-unstable.
Specifications
| Clone | IHC410 |
| Source | Mouse Monoclonal |
| Positive Control | Colon Mucosa, Colon Carcinoma |
| Dilution Range | 1:50-1:200 |
Quantity
1.00
Select Volume
3 slides/package

Reviews
There are no reviews yet.